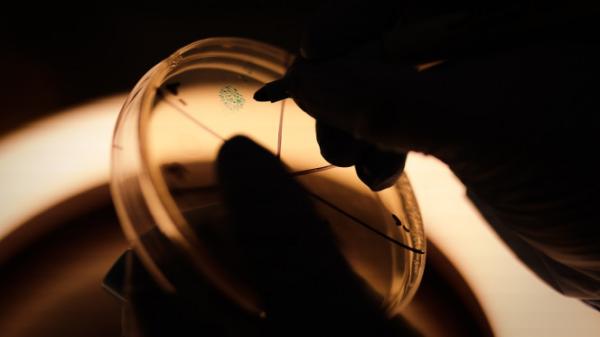

El emprendimiento que le apuesta a un virus
Sciphage es la primera planta en Colombia de bacteriófagos, el virus que destruye bacterias. Una alternativa para los antibióticos.Un antibiótico es como una bomba. Donde cae puede matar a enemigos o aliados. En el caso de los humanos y animales, puede acabar con bacterias que causan enfermedades al igual que con las que ayudan, por ejemplo, a la digestión.
Para agravar la situación, las bacterias se han vuelto resistentes a muchos de ellos y han dejado a pacientes infectados sin alternativas de tratamiento.
Por eso la ciencia hoy está estudiando un enemigo histórico de las bacterias: los bacteriófagos o fagos. Estos virus inoculan en las bacterias su material genético y tras reproducirse dentro de esta, la hacen estallar. Pero, a diferencia del antibiótico, estos se especializan en unas bacterias específicas.
En Colombia ha nacido la primera planta productora de fagos, Sciphage, un emprendimiento que tiene sus orígenes en la Universidad de los Andes, con el liderazgo de la profesora Martha Vives y el Grupo de Microbiología Ambiental y Bioprospección del Centro de Investigaciones Microbiológicas - CIMIC.
SalmoFree, el coctel de bacteriófagos creado en el laboratorio, capaz de controlar la bacteria Salmonella, que provoca graves problemas digestivos al ingerirla en alimentos, fue patentado en 2017 y licenciado a la Empresa de Ciencia y Tecnología de Fagos - Sciphage.

La planta está localizada en Mosquera, Cundinamarca. La construcción, el montaje y la puesta en marcha se hizo en el marco del proyecto de Sistema General de Regalías del Ministerio de Ciencia, Tecnología e Innovación.
En la planta se pueden producir cualquier producto a base de bacteriófagos, aunque comenzará con un coctel de fagos para el sector agropecuario, que controla la salmonella y que está patentado en Colombia, Estados Unidos y Brasil.
La planta comenzará su producción enfocada en el sector avícola, produciendo SalmoFree®, beneficiando con este a productores de pollos y a consumidores.
Sciphage surgió por el potencial que veían los investigadores en los fagos, “Vimos que la única manera para poder llevar eso que hacíamos, y que podía realmente impactar a la sociedad, era a través de un emprendimiento”, dice Viviana Clavijo, gerente general de Sciphage, y quien enumera los retos de un emprendimiento en este campo.
La tasa de retorno en ciencia
El emprendimiento en ciencia es diferente, dice Clavijo. Este, en un primer momento, puede no ser muy atractivo por sus costos y trae un perfil de inversionistas particular, quienes van más allá de un interés económico.
La microbióloga y doctora en Ciencias de la Universidad de los Andes habla de dos factores que pueden dificultar encontrar financiación. Por un lado, son emprendimientos que requieren grandes inversiones y por el otro, toman un tiempo en empezar a generar retornos, aunque la espera, por lo general, trae mayores frutos.
Otro reto es conseguir clientes, que en emprendimientos de ciencia pueden presentar una dificultad adicional y es hacer que los compradores entiendan el producto. Se les está vendiendo un virus en botella, por lo que las prevenciones no faltan. Para esto el equipo ha tenido que dejar a un lado los términos del laboratorio y utilizar un lenguaje más amigable con sus clientes.
Paradójicamente, la pandemia por COVID 19 ha ayudado a que haya “una creencia en la ciencia, en que puede resolver problemas que tenemos como humanidad”, dice Clavijo. Pero esto no despeja el reto de ilustrar a los potenciales compradores de estos microorganismos.
La omnipresencia de los fagos
“Hay más fagos que bacterias, que plantas, que animales, cualquier cosa que se les pueda ocurrir, hay más fagos. Eso significa que nosotros hemos aprendido a convivir con ellos”, explica Santiago Hernández, director científico de Sciphage.
La ventaja de los fagos, y que los diferencia de otros antimicrobianos, es que son específicos y eliminan solo la bacteria problema en animales, plantas o humanos. Algo súper importante si se tiene en cuenta el beneficio que traen otras bacterias.
En el mundo se utilizan en la llamada fagoterapia, que es el uso de fagos para controlar poblaciones bacterianas.
Además del uso agrícola con el que trabaja la nueva planta, se pueden utilizar para tratar enfermedades infecciosas bacterianas, siendo este apenas otro uso de los muchos que se siguen investigando en el mundo.
“Nos ayuda a controlar el problema de la resistencia, porque también sabemos que cuando utilizamos fagos en bacterias resistentes, también retrocedemos esa resistencia”, explica Hernández como otra de las ventajas de los fagos.
En Estados Unidos, la Administración de Alimentos y Medicamentos (FDA, por su sigla en inglés) ha aprobado el uso como tratamiento compasivo alternativo, es decir, en pacientes que tengan una bacteria resistente a los antibióticos.
Según la directora Clavijo, la meta de Sciphage es llegar a hacer referente en salud animal y posteriormente dar el salto al tratamiento clínico, que fue una de las motivaciones que los llevó a convertirse en científicos emprendedores.

Equipo de la empresa de Ciencia y Tecnología de Fagos - Sciphage